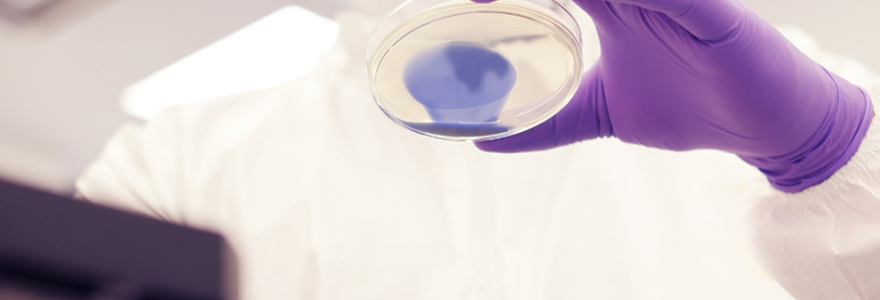
bio contamination

L’examen des sédiments urinaires constitue un pilier fondamental du diagnostic biologique, offrant des informations cruciales sur la santé rénale et urinaire des patients. Longtemps réalisée manuellement au microscope, cette analyse connaît aujourd’hui une véritable révolution technologique grâce à l’avènement des…
Lire la suite
L’hallux valgus, communément appelé « oignon », est une déformation progressive du gros orteil qui peut causer des douleurs importantes et affecter votre qualité de vie. Cette pathologie touche environ 23% de la population adulte et sa prévalence augmente avec l’âge. Bien…
Lire la suite
La pressothérapie est une technique thérapeutique de plus en plus populaire pour améliorer la circulation sanguine et lymphatique. Cette méthode non invasive utilise la compression pneumatique pour stimuler le flux sanguin et drainer les toxines du corps. Avec ses multiples…
Lire la suite
La lune, avec son cycle constant, fascine depuis toujours l’homme. Sa beauté mystique a inspiré d’innombrables mythes et légendes. Mais cette fascination pour la lune a une portée plus profonde que la simple admiration. De récentes recherches scientifiques ont confirmé…
Lire la suite
Besoin urgent d’un médecin de garde à Montpellier ? Des solutions existent pour dénicher rapidement le professionnel de santé qu’il vous faut. Entre la recherche en ligne, le bouche-à-oreille dans votre quartier ou le recours à SOS Médecin, plusieurs options…
Lire la suite
L’accessibilité aux médicaments est primordiale, surtout en cas d’urgence. Des situations imprévues peuvent survenir à tout moment, nécessitant une intervention médicale immédiate. Pour répondre à ce besoin, les pharmacies de garde jouent un rôle vital. Elles assurent la disponibilité de…
Lire la suite
Il peut être intimidant et difficile pour les patients souffrant de problèmes de santé liés au pied de trouver le bon docteur et chirurgien du pied à Nice. Dans une région avec de nombreux professionnels de la santé spécialisés, il…
Lire la suiteLa pilule contraceptive est un moyen de contraception très efficace. Cependant, il est important de bien la suivre pour qu’elle soit efficace. Si vous oubliez une pilule, il existe différentes façons de rattraper votre retard. Cas n°1 : oubli de…
Lire la suite
La bio contamination, par définition, est la contamination d’une matière, d’une surface, d’un appareil, d’un liquide, de l’air ou d’un individu par des micro-organismes. Parmi les contaminants spécifiques, on retrouve les allergènes et les agents transmissibles non conventionnels ou ATNC….
Lire la suite
Il existe deux principales sous-espèces de cannabis. Il y a le cannabis sativa et le cannabis Indica. La sativa est une convenance pour l’énergie alors que l’indica est un renforcement des sentiments d’apaisement et de bien être. Sur le plan santé, ces variétés…
Lire la suite